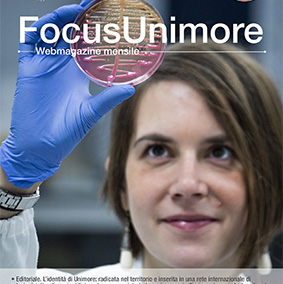

L’Università di Modena e Reggio Emilia – Unimore è un grande Ateneo multidisciplinare, e proprio per questo caratterizzato da molteplici sfaccettature, competenze, prospettive fino a qualche tempo fa spesso non conosciute neppure dagli stessi componenti dell’Ateneo.
FocusUnimore: nel segno della curiosità e della scoperta